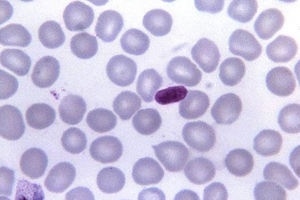

Newsletter DPT Nro. 45
ISSN 2618-236X
Enero-Febrero 2020
CUMBRE MUNDIAL DEL CAMBIO CLIMATICO (COP-25)
La vigésimo quinta Conferencia de las Partes en la Convención de las Naciones Unidas sobre el Cambio Climático (COP-25) se celebró en Madrid entre el 2 y el 15 de diciembre de 2019, con más de 25.000 participantes provenientes de 200 países.
Durante la exposición de cierre de la reunión la presidenta de la COP-25 y ministra de Medio Ambiente de Chile, Carolina Schmidt, señaló que no estaba satisfecha con los resultados, aun cuando “hemos puesto corazón y esfuerzo por buscar acuerdos”, e instó a dar “una respuesta más sólida, urgente y ambiciosa para enfrentar la crisis climática”.


NOTA INSTITUCIONAL
Se realizó el X Congreso Iberoamericano de Tecnologías de Apoyo a la Discapacidad – IBERDISCAP 2019. CABA
El X Congreso Iberoamericano de Tecnologías de Apoyo a la Discapacidad – “IBERDISCAP 2019″ se realizó entre el 20 y el 22 de noviembre de 2019 en el Polo Científico Tecnológico de Buenos Aires. Participaron investigadores y profesionales de las áreas de salud, ingeniería y educación interesados en el desarrollo de tecnología para la inclusión de personas con discapacidad.
NOTAS DE INVESTIGACION
Avances en neuroprótésis
Mediante control compartido con apoyo robótico


Nuevos aportes sobre capacidad regenerativa humana
Su potencial en medicina regenerativa
Amplían el rango de mutaciones genéticas que pueden corregirse
Con fines terapéuticos


Micromáquinas animadas
Se comportarán como moléculas biológicas y microorganismos
Imagen: KENPEI – KENPEI’s photo
Microrrobótica blanda continua
Sus posibilidades y desafíos
Imagen: Steven Glenn, Laboratory and Consultation Division, USCDCP

Resultados clínicos en psicoterapia
Revisiones sustentadas en grandes muestras
CUESTIONES DE INTERES
CAMBIO CLIMATICO GLOBAL
La siguiente reseña –reducida y parcial- tiene como único propósito estimular la lectura de la amplia literatura disponible sobre tan relevante temática

Nota del Editor: El editor no se responsabiliza por los conceptos u opiniones vertidos en las entrevistas, artículos y documentos reseñados en este Newsletter, los cuales son de exclusiva responsabilidad de los respectivos entrevistados, autores o colaboradores.

STAFF DEL NEWSLETTER DPT
Sr. Guillermo Gómez Galizia
Presidente de la Fundación Instituto para el Desarrollo Productivo y Tecnológico Empresarial de la Argentina (DPT)
Lic. José Luis Tesoro
Coordinador Editorial
Integrantes del Comité Editorial
Dr. Amadeo Cellino
Dra. Mariana Iurman
Dr. Javier Vilosio
ISSN 2618-236X

